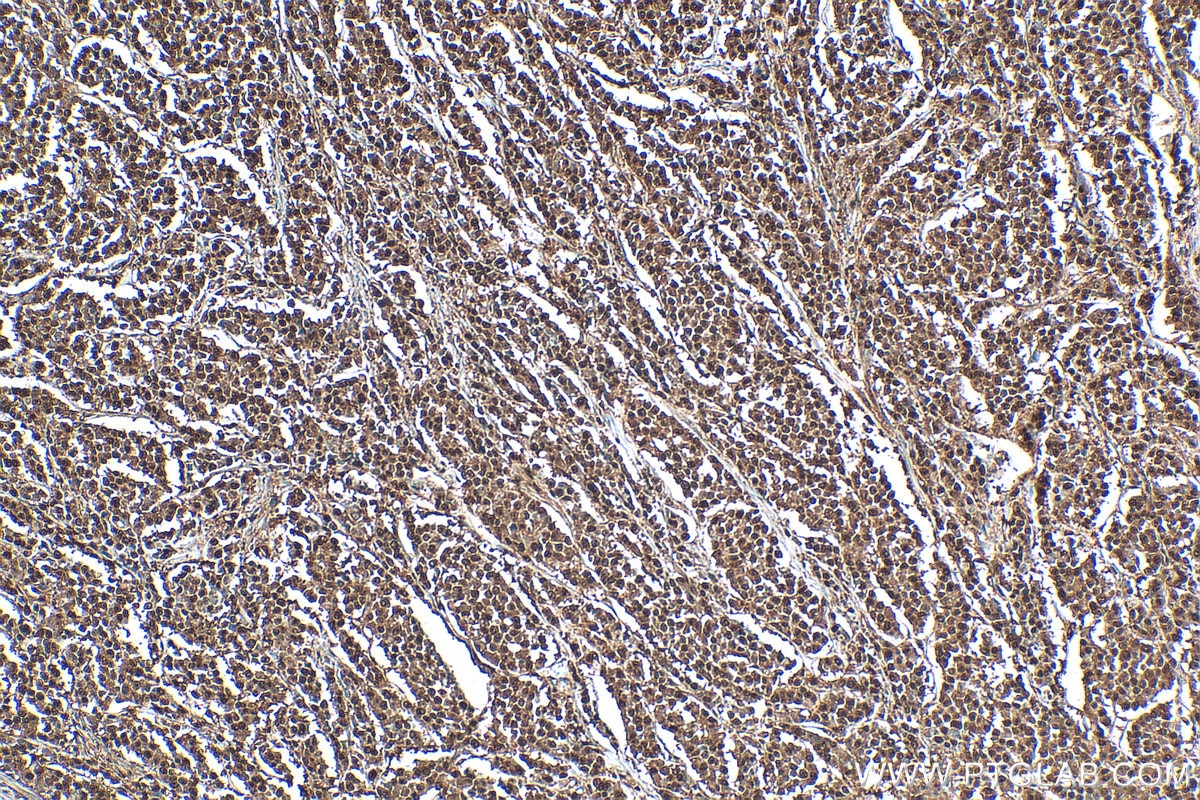

Tested Applications
| Positive WB detected in | A2780 cells, HeLa cells, mouse brain tissue, rat brain tissue, HT-1080 cells, NIH/3T3 cells, C6 cells, PC-12 cells |
| Positive IHC detected in | human colon cancer tissue, mouse brain tissue Note: suggested antigen retrieval with TE buffer pH 9.0; (*) Alternatively, antigen retrieval may be performed with citrate buffer pH 6.0 |
| Positive IF/ICC detected in | HeLa cells |
| Positive FC (Intra) detected in | Jurkat cells |
Recommended dilution
| Application | Dilution |
|---|---|
| Western Blot (WB) | WB : 1:2000-1:12000 |
| Immunohistochemistry (IHC) | IHC : 1:50-1:500 |
| Immunofluorescence (IF)/ICC | IF/ICC : 1:50-1:500 |
| Flow Cytometry (FC) (INTRA) | FC (INTRA) : 0.40 ug per 10^6 cells in a 100 µl suspension |
| It is recommended that this reagent should be titrated in each testing system to obtain optimal results. | |
| Sample-dependent, Check data in validation data gallery. | |
Published Applications
| KD/KO | See 2 publications below |
| WB | See 18 publications below |
| IHC | See 2 publications below |
| IF | See 2 publications below |
| IP | See 4 publications below |
| CoIP | See 2 publications below |
Product Information
10077-1-AP targets Importin Beta in WB, IHC, IF/ICC, FC (Intra), IP, CoIP, ELISA applications and shows reactivity with human, mouse, rat samples.
| Tested Reactivity | human, mouse, rat |
| Cited Reactivity | human, mouse |
| Host / Isotype | Rabbit / IgG |
| Class | Polyclonal |
| Type | Antibody |
| Immunogen |
CatNo: Ag0122 Product name: Recombinant human KPNB1 protein Source: e coli.-derived, PGEX-4T Tag: GST Domain: 409-612 aa of BC003572 Sequence: AMPTLIELMKDPSVVVRDTAAWTVGRICELLPEAAINDVYLAPLLQCLIEGLSAEPRVASNVCWAFSSLAEAAYEAADVADDQEEPATYCLSSSFELIVQKLLETTDRPDGHQNNLRSSAYESLMEIVKNSAKDCYPAVQKTTLVIMERLQQVLQMESHIQSTSDRIQFNDLQSLLCATLQNVLRKVQHQDALQISDVVMASLL Predict reactive species |
| Full Name | karyopherin (importin) beta 1 |
| Calculated Molecular Weight | 97 kDa |
| Observed Molecular Weight | 90-97 kDa |
| GenBank Accession Number | BC003572 |
| Gene Symbol | KPNB1 |
| Gene ID (NCBI) | 3837 |
| RRID | AB_2133977 |
| Conjugate | Unconjugated |
| Form | Liquid |
| Purification Method | Antigen affinity purification |
| UNIPROT ID | Q14974 |
| Storage Buffer | PBS with 0.02% sodium azide and 50% glycerol, pH 7.3. |
| Storage Conditions | Store at -20°C. Stable for one year after shipment. Aliquoting is unnecessary for -20oC storage. 20ul sizes contain 0.1% BSA. |
Background Information
Importin beta1, also known karyopherin beta or KPNB1, is a nuclear transport receptor that plays a key role in the nuclear import process. Importin beta1 and importin alpha work in concert to transport cargo into the nucleus, functioning as an essential component of the classical nuclear localization signal (NLS) pathway. Elevated expression of importin beta1 has been found in cervical tumors. (22125623)
Protocols
| Product Specific Protocols | |
|---|---|
| FC protocol for Importin Beta antibody 10077-1-AP | Download protocol |
| IF protocol for Importin Beta antibody 10077-1-AP | Download protocol |
| IHC protocol for Importin Beta antibody 10077-1-AP | Download protocol |
| WB protocol for Importin Beta antibody 10077-1-AP | Download protocol |
| Standard Protocols | |
|---|---|
| Click here to view our Standard Protocols |
Publications
| Species | Application | Title |
|---|---|---|
Cell Res Neddylation of PTEN regulates its nuclear import and promotes tumor development. | ||
Cell Rep CGG repeats in the human FMR1 gene regulate mRNA localization and cellular stress in developing neurons | ||
Oncogene KPNB1 inhibition disrupts proteostasis and triggers unfolded protein response-mediated apoptosis in glioblastoma cells.
| ||
J Transl Med TC2N inhibits distant metastasis and stemness of breast cancer via blocking fatty acid synthesis | ||
Virol Sin African Swine Fever Virus MGF360-12L Inhibits Type I Interferon Production by Blocking the Interaction of Importin α and NF-κB Signaling Pathway. | ||
PLoS Pathog Phospholipid scramblase 1 interacts with influenza A virus NP, impairing its nuclear import and thereby suppressing virus replication. |
Reviews
The reviews below have been submitted by verified Proteintech customers who received an incentive for providing their feedback.
FH María (Verified Customer) (02-08-2022) | Works for WB (1:1000) and IF in permeabilized cells (1:100 ON). Validated with siRNA
|